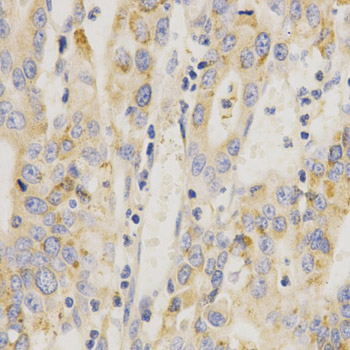

Anti-MAP2K6 Antibody
A34985
ApplicationsImmunoFluorescence, Western Blot, ImmunoHistoChemistry
Product group Antibodies
ReactivityHuman, Mouse, Rat
Overview
- SupplierAntibodies.com
- Product NameAnti-MAP2K6 Antibody
- Delivery Days Customer7
- ApplicationsImmunoFluorescence, Western Blot, ImmunoHistoChemistry
- CertificationResearch Use Only
- ClonalityPolyclonal
- Concentration1.0 mg/ml
- ConjugateUnconjugated
- HostRabbit
- Scientific DescriptionRabbit polyclonal antibody to MAP2K6
- ReactivityHuman, Mouse, Rat
- UNSPSC12352203

![Whole cell extract (30 μg) was separated by 10% SDS-PAGE, and the membrane was blotted with MEK6 antibody [N1C3] (GTX107445) diluted at 1:1000. The HRP-conjugated anti-rabbit IgG antibody (GTX213110-01) was used to detect the primary antibody.](https://www.genetex.com/upload/website/prouct_img/normal/GTX107445/GTX107445_40037_20220401_WB_2_w_23060120_679.webp)